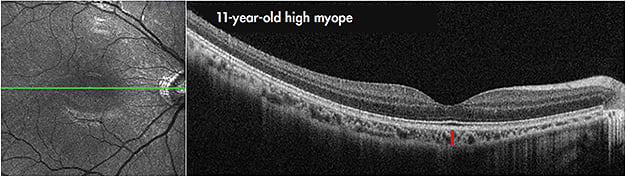
Figure 4. Example of a foveal-centred OCT scan from an 11-year-old, highly myopic male (spherical equivalent refraction –7.00D, axial length 26.86mm). Note the substantial thinning of the choroid evident in this patient (mean subfoveal choroidal thickness of 117µm). The red line illustrates subfoveal choroidal thickness.

Myopia is a growing global problem, with evidence of a dramatic rise in myopia prevalence in recent decades in many countries around the world.1 Although the highest levels of myopia are typically seen in developed East Asian countries, significant increases in myopia prevalence have also been observed in Europe2 and the United States.3 These increased levels of myopia are accompanied by elevated risks of numerous sight-threatening pathological complications such as retinal detachment and myopic maculopathy.4
The significant public health implications of rising myopia levels have resulted in renewed research interest in this area. An important recent trend in research examining the etiology and management of myopia is the application of high-resolution optical coherence tomography (OCT) imaging, which has provided important new insights regarding the mechanisms regulating eye growth and the development of myopia in the human eye along with an improved understanding of a range of different myopia management options.
A ROLE FOR THE CHOROID IN HUMAN MYOPIA ETIOLOGY
Animal research suggests that the choroid plays an important role in the process of eye growth regulation and in the development and progression of myopia; predictable changes in the thickness of the choroid tend to occur in response to visual stimuli that are also known to influence eye growth and refractive error development.5 Visual stimuli that cause an increase in eye growth and myopia development (e.g., hyperopic image blur) also consistently result in a rapid choroidal thinning response in a wide range of animal species, whereas stimuli that slow eye growth (e.g., myopic image blur) are accompanied by a rapid thickening of the choroid. Although the choroid’s precise role in visually guided eye growth is still not fully understood, it has been proposed that the choroid may relay signals or growth factors from the retina to the sclera, or alternatively, the choroid may be a source of growth factors that influence scleral growth and eventually result in refractive error development.
Recent research utilizing high-resolution methods to image the choroid have confirmed that the human choroid also appears to exhibit rapid changes in thickness in response to retinal image blur,6,7 at least in the short-term, similar to the changes that have previously been documented in animal research (although notably smaller in magnitude). Figure 1 provides an overview of these choroidal changes observed in response to optical blur. Although these choroidal responses to image blur in the human eye support a role for the choroid in the mechanisms regulating human eye growth, the short-term nature of these changes does not provide a definitive link between choroidal changes and myopia. The relatively small magnitude of these changes suggests that these short-term choroidal responses may represent a biomarker for the signals underlying changes in longer-term eye growth.

A large number of recent cross-sectional studies using OCT imaging in healthy adults have also shown that the presence of refractive error is associated with choroidal thickness changes, with more myopic refractive errors (and longer axial lengths) consistently being associated with a thinner choroid.8 Similarly, myopic children also have thinner choroids compared to emmetropic children, suggesting that choroidal thinning associated with myopia development is likely to occur early in the process of refractive error development (Figure 2).9,10
![Figure 2. Example of high-resolution, foveal-centered OCT scans from a 12-year-old myopic child (spherical equivalent –2.00DS, axial length 24.17mm) [top]) and a 12-year-old emmetropic child (spherical equivalent +0.25DS, axial length 23.87 [bottom]). Note the substantially reduced thickness of the choroid in the myopic child (mean subfoveal choroidal thickness of 238µm) compared to the emmetropic child (mean 392µm). The red line illustrates subfoveal choroidal thickness measures.](https://res.cloudinary.com/broadcastmed/image/fetch/q_auto,f_auto,dpr_auto/https://www.clspectrum.com/media/nxmfx0o5/cls_sep_2201.jpg)
A small number of longitudinal studies of choroidal thickness in childhood have also been conducted recently that have helped to establish a clearer link between choroidal changes and eye growth in the human eye.11,12 In a longitudinal study of 101 Australian schoolchildren (aged 10 to 15, including both myopic and emmetropic children) examined over an 18-month period, the choroid underwent a significant increase in thickness over time. The longitudinal changes in choroidal thickness, however, were also found to be significantly associated with the rate of eye growth in childhood, with slower eye growth associated with more choroidal thickening and faster eye growth associated with less thickening over time. Myopic children undergoing more rapid eye growth (i.e., faster progression) therefore often exhibited a thinning of the choroid (Figure 3).11

Other longitudinal studies of pediatric choroidal thickness have also reported similar changes in children, with myopia progression typically being associated with significant thinning of the choroid. In a 15-month longitudinal study of European children, Fontaine et al also reported that choroidal thickness at their baseline study visit was associated with the rate of eye growth, with a thinner choroid at baseline being associated with more rapid eye growth.12 These longitudinal studies indicate that choroidal thickness appears to be a marker for eye growth and myopia progression in the human eye, which suggests that clinical monitoring of choroidal thickness is likely to provide useful clues for identifying children at risk for the development and progression of myopia. Because normal eye growth is generally associated with a small magnitude thickening of the choroid over time, children exhibiting thinning of the choroid appear to be at increased risk of more rapid eye growth and, hence, myopia development and progression.
Choroidal thickness is also substantially reduced in subjects who have high myopia (generally defined as more than 6.00D of myopia or an axial length of > 26mm) (Figure 4).13-15 There is also evidence to suggest that this marked choroidal thinning plays a role in the pathogenesis of reduced vision14 and certain pathologies associated with high myopia (e.g., staphyloma, myopic maculopathy, and lacquer cracks).13,15,16 Clinical monitoring of choroidal thickness in high myopes is therefore also likely to be useful in identifying those patients at risk of developing ocular pathology associated with myopia. Wang and colleagues reported a strong link between the presence of lacquer cracks and choroidal thinning in high myopia, with a central choroidal thickness of less than 59µm reported to be a useful biomarker for predicting the presence of lacquer cracks with good sensitivity and specificity.16
MECHANISMS UNDERLYING MYOPIA CONTROL INTERVENTIONS
A range of clinical interventions have recently emerged aiming to slow eye growth and, hence, reduce myopia progression through environmental, optical, or pharmacological means. Clinical trials have shown promise for a number of these methods to significantly reduce the development and/or the progression of myopia in childhood.17 Research utilizing high-resolution OCT imaging has also provided important insights into the potential mechanisms underlying these interventions.
Outdoor Activity and Myopia Since the first report in the 1990s of an association between more outdoor time and less myopia progression in Finnish children,18 a large number of epidemiological studies have produced evidence indicating that spending more time outdoors in childhood protects against the development of myopia.19 A study of Australian children (the Role of Outdoor Activity in Myopia [ROAM] study) assessed personal ambient light exposure (measured with wearable light sensors) and axial eye growth over 18 months. This study demonstrated that children who were habitually exposed to low ambient light levels throughout the day (less than 60 minutes per day on average of bright outdoor light) also exhibited faster axial eye growth compared to children exposed to higher daily amounts of bright ambient light.20 Children’s (objectively measured) physical activity levels were not associated with eye growth in this study, indicating that it is likely that exposure to bright-intensity (visible) light outdoors is involved in the protective effects of outdoor activities upon eye growth. This is also consistent with animal studies showing that experimental myopia can be prevented by exposure to bright light.21
A recent randomized controlled trial in Taiwan, in which children in the intervention group were encouraged to increase their outdoor time each day (by ~80 minutes each day during school) has shown that increasing outdoor time significantly reduced axial elongation and myopia progression compared to a control group.22 These researchers also assessed personal light exposure using wearable sensors and found that greater exposure to bright light during the day was associated with less myopic shift in refraction over 12 months. Taken together, these results suggest that spending less than 60 minutes per day in bright outdoor light is a risk factor for more rapid eye growth and, hence, the development and progression of myopia and that spending at least two hours a day on outdoor activities is likely to reduce myopia risk. Animal studies suggest that the outdoor effects are likely to be mediated by visible outdoor light rather than by ultraviolet (UV) exposure (as artificial bright light without UV wavelengths still protects against experimental myopia development21), so UV protection strategies when outdoors should still be encouraged. The high-intensity brightness of outdoor light (up to 100,000 lux on a sunny day) suggests that even with a hat and sunglasses, light levels outdoors are substantially brighter compared to those encountered indoors.
Studies with animals also indicate that along with slowing eye growth, daily exposure to bright light is also associated with a thickening of the choroid,23 and it has been suggested that choroidal thickening (potentially from light-induced retinal dopamine release) may be involved in the mechanisms underlying the effects of bright light upon eye growth. Although more work is required to understand the effects of bright light on the human choroid, a recent study reported that daily morning bright light therapy for a seven-day period (delivered through the use of light therapy glasses that are effective in treating sleep disorders and seasonal depression, presumably through the effects of light upon circadian rhythms) resulted in a small but significant increase in choroidal thickness that was most prominently observed in the afternoon/evening following the light therapy.24
ORTHOKERATOLOGY AND MYOPIA
Orthokeratology contact lenses are normally worn overnight and deliberately flatten the central cornea to correct myopic refractive errors. In addition, these contact lenses are also effective at reducing the progression of myopia (i.e., the rate of axial elongation is significantly slowed with orthokeratology treatment). Randomized clinical trials demonstrate a slowing of axial elongation of up to ~50% associated with orthokeratology lens wear in myopic children compared to control groups.25
It has been proposed that the myopia control effects of orthokeratology lenses may result from induced peripheral myopic image blur associated with ortho-k; to flatten the central cornea, these lenses also cause a steepening of the midperiphery, which induces peripheral myopic defocus. To better understand the potential mechanisms underlying orthokeratology’s effects on myopia progression, a number of recent studies have examined whether orthokeratology treatment leads to changes in choroidal thickness.
Two recent reports in Chinese children indicate that significant choroidal thickening occurs during orthokeratology lens wear.26,27 Interestingly, the choroidal thickness changes in these studies are not localized only to peripheral regions, as increases in subfoveal choroidal thickness were also observed. These studies indicate that increases in choroidal thickness are evident after three weeks of ortho-k lens wear and are still present following six months of wear. Although further research is required to better understand the link between the choroidal thickening in ortho-k and the longer-term effects of this treatment on eye growth, these findings support a potential role for the choroid in the mechanisms underlying ortho-k’s myopia control effects.
SOFT MULTIFOCALS AND MYOPIA
A number of different soft contact lenses have also been investigated in clinical trials in recent years to examine their potential efficacy for controlling myopia progression in childhood. Although different contact lens designs have been trialed, including custom lens designs28 and commercially available bifocal or multifocal lenses (typically with a center-distance design29), these lenses all generally aim to introduce peripheral myopic optical blur as an approach for slowing myopia progression. Clinical trials examining the impact of these contact lenses on myopia progression and axial elongation in children (compared to either single-vision spectacles or contact lenses as a control group) have shown significant positive myopia control effects, with a slowing of axial elongation of about 30% to 50% observed across these trials. Future research will hopefully reveal whether these soft lenses for myopia control that introduce peripheral myopic defocus also result in choroidal changes, which, as mentioned previously, has recently been observed for orthokeratology lenses.
ATROPINE AND MYOPIA
Pharmaceutical agents that block the parasympathetic system (i.e., anticholinergic drugs) such as atropine have also demonstrated in randomized clinical trials to be effective at slowing myopia progression in children.17 Although the exact mechanisms of how these pharmacological agents exert their effects on eye growth are still not fully understood, meta-analyses examining outcomes from a variety of different myopia control interventions generally indicate that treatments with atropine tend to exhibit the greatest effects in slowing myopia progression.17
A clinical trial involving nightly use of 1.0% atropine in myopic children in Singapore reported a 77% slowing of myopia progression compared to a control group.30 Atropine at this dosage, however, does lead to a range of significant ocular side effects, including blurred near vision, glare, and photophobia, due to its cycloplegic and mydriatic effects.
More recent research has examined whether lower doses of atropine (that have fewer unwanted ocular side effects) also exhibit efficacy for myopia control. In a randomized controlled trial, myopic children were assigned to receive either 0.5%, 0.25%, 0.1%, or 0.01% atropine once nightly.31 A dose-dependent myopia control effect was observed over the first two years of this study (with stronger effects with higher doses); however, clinically significant (~50% slowing of myopia progression) myopia control effects were still observed with the lowest dose (0.01%) used in the study. The low-dose (0.01%) atropine also resulted in substantially lower ocular and visual side effects (i.e., less mydriatic and cycloplegic effects) and, furthermore, also exhibited limited rebound effects (i.e., the substantial increase in myopia progression following cessation of treatment that is typically observed for higher doses of atropine) following cessation of treatment. This suggests that 0.01% atropine provides a clinically significant slowing of myopia progression while reducing many of the unwanted effects associated with higher doses of atropine.
While the majority of evidence for significant myopia control effects with atropine come from studies of East Asian pediatric populations, there is also some evidence suggesting that atropine (at least in higher doses such as 0.5%) is also effective in controlling myopia progression in non-Asian children.32 A number of randomized controlled studies are also currently underway examining the effectiveness of low-dose atropine in non-Asian children.
Recent studies have also shown that in the short term, anticholinergic agents such as atropine and homatropine also result in a significant choroidal thickening.33,34 The interaction between anticholinergic agents and choroidal responses to optical blur has also been examined. Chiang and Phillips recently reported that 0.5% atropine (instilled approximately one day prior to exposure to optical blur) abolished the normal thinning of the choroid that occurs in response to hyperopic optical blur.35 Similar findings were reported in a study examining choroidal changes following 2% homatropine, in which the instillation of homatropine also eliminated the choroidal thinning effect following 60 minutes of exposure to monocular hyperopic blur.33 These findings support a potential involvement of the choroid in the mechanisms underlying the myopia control effects of antimuscarinic drugs, and the findings suggest that these agents appear to inhibit the eye’s response to hyperopic image blur.
CONCLUSIONS
The use of high-resolution ocular imaging methods in myopia research has enabled our understanding of the ocular mechanisms regulating eye growth and myopia development in the human eye to advance considerably in recent years. Consistent with findings from animal research, substantial evidence has emerged supporting an important role for the choroid in human eye growth regulation. Choroidal thickness changes appear to be a biomarker for eye growth, with choroidal thinning typically associated with faster eye growth (and hence more rapid myopia progression) and a thickening of the choroid associated with a slowing of eye growth. The association between eye growth and choroidal thickness suggests that the clinical monitoring of choroidal thickness is likely to provide important insights in identifying patients who are at higher risk of myopia development and progression.
A number of promising myopia control interventions have also emerged in recent years, with large-scale clinical trials demonstrating significant effects for a number of interventions to slow eye growth and influence myopia development and progression in childhood. The links between choroidal thickness and eye growth, coupled with the rapid nature of choroidal thickness changes in response to visual stimuli, suggest that studies examining the short-term choroidal thickness changes in response to myopia control interventions will provide useful information regarding their mechanisms of action and, potentially, their impact on longer-term eye growth. Studies examining the short-term response of the choroid to bright light exposure, orthokeratology, and antimuscarinic agents have documented a thickening of the choroid associated with each of these myopia control interventions, suggesting a potential contribution or reaction of the choroid to their antimyopiagenic actions. Additional research utilizing high-resolution ocular imaging methods to more clearly understand the choroidal changes associated with myopia control interventions has the potential to enhance our understanding of the mechanisms of these interventions. It will also likely be important for future work to optimize treatment efficacy, thus further retarding myopia development and progression. CLS
REFERENCES
- Holden BA, Fricke TR, Wilson DA, et al. Global prevalence of myopia and high myopia and temporal trends from 2000 through 2050. Ophthalmology. 2016 May;123:1036-1042.
- Williams KM, Bertelsen G, Cumberland P, et al. Increasing prevalence of myopia in Europe and the impact of education. Ophthalmology. 2015 Jul;122:1489-1497.
- Vitale S, Sperduto RD, Ferris FL 3rd. Increased prevalence of myopia in the United States between 1971-1972 and 1999-2004. Arch Ophthalmol. 2009 Dec;127:1632-1639.
- Flitcroft DI. The complex interactions of retinal, optical and environmental factors in myopia aetiology. Prog Retin Eye Res. 2012 Nov;31:622-660.
- Nickla DL, Wallman J. The multifunctional choroid. Prog Retin Eye Res. 2010 Mar;29:144-168.
- Read SA, Collins MJ, Sander BP. Human optical axial length and defocus. Invest Ophthalmol Vis Sci. 2010 Dec;51:6262-6269.
- Chiang ST, Phillips JR, Backhouse S. Effect of retinal image defocus on the thickness of the human choroid. Ophthalmic Physiol Opt. 2015 Jul;35:405-413.
- Harb E, Hyman L, Gwiazda J, et al. Choroidal thickness profiles in myopic eyes of young adults in the correction of myopia evaluation trial cohort. Am J Ophthalmol. 2015 Jul;160:62-71.e2.
- Read SA, Collins MJ, Vincent SJ, Alonso-Caneiro D. Choroidal thickness in myopic and nonmyopic children assessed with enhanced depth imaging optical coherence tomography. Invest Ophthalmol Vis Sci. 2013 Nov;54:7578-7586.
- Xiong S, He X, Deng J, et al. Choroidal thickness in 3001 Chinese children aged 6 to 19 years using swept-source OCT. Sci Rep. 2017 Mar 22;7:45059.
- Read SA, Alonso-Caneiro D, Vincent SJ, Collins MJ. Longitudinal changes in choroidal thickness and eye growth in childhood. Invest Ophthalmol Vis Sci. 2015 May;56:3103-3112.
- Fontaine M, Gaucher D, Sauer A, Speeg-Schatz C. Choroidal thickness and ametropia in children: A longitudinal study. Eur J Ophthalmol. 2017 Jun 7:0.
- Ikuno Y, Jo Y, Hamasaki T, Tano Y. Ocular risk factors for choroidal neovascularization in pathologic myopia. Invest Ophthalmol Vis Sci. 2010 Jul;51:3721-3725.
- Nishida Y, Fujiwara T, Imamura Y, Lima LH, Kurosaka D, Spaide RF. Choroidal thickness and visual acuity in highly myopic eyes. Retina. 2012 Jul;32:1229-1236.
- Zhou LX, Shao L, Xu L, Wei WB, Wang YX, You QS. The relationship between scleral staphyloma and choroidal thinning in highly myopic eyes: The Beijing eye study. Sci Rep. 2017 Aug 29;7:9825.
- Wang NK, Lai CC, Chou CL, et al. Choroidal thickness and biometric markers for the screening of lacquer cracks in patients with high myopia. PLoS One. 2013;8(1):e53660.
- Huang J, Wen D, Wang Q, et al. Efficacy comparison of 16 interventions for myopia control in children: A network meta-analysis. Ophthalmology. 2016 Apr;123:697-708.
- Pärssinen O, Lyyra AL. Myopia and myopic progression among schoolchildren: A three-year follow-up study. Invest Ophthalmol Vis Sci. 1993 Aug;34:2794-2802.
- Xiong S, Sankaridurg P, Naduvilath T, et al. Time spent in outdoor activities in relation to myopia prevention and control: A meta-analysis and systematic review. Acta Ophthalmol. 2017 Sep;95:551-566.
- Read SA, Collins MJ, Vincent SJ. Light exposure and eye growth in childhood. Invest Ophthalmol Vis Sci. 2015 Oct;56:6779-6787.
- Ashby R, Ohlendorf A, Schaeffel F. The effect of ambient illuminance on the development of deprivation myopia in chicks. Invest Ophthalmol Vis Sci. 2009 Nov;50:5348-5354.
- Wu PC, Chen CT, Lin KK, et al. Myopia prevention and outdoor light intensity in a school-based cluster randomized trial. Ophthalmology. 2018 Aug;125:1239-1250.
- Lan W, Feldkaemper M, Schaeffel F. Bright light induces choroidal thickening in chickens. Optom Vis Sci. 2013 Nov;90:1199-1206.
- Read SA, Pieterse EC, Alonso-Caneiro D, et al. Daily morning light therapy is associated with an increase in choroidal thickness in healthy young adults. Sci Rep. 2018 May;8:8200.
- Cho P, Cheung SW. Retardation of myopia in orthokeratology (ROMIO) study: A 2-year randomized clinical trial. Invest Ophthalmol Vis Sci. 2012 Oct 11;53:7077-7085.
- Chen Z, Xue F, Zhou J, Qu X, Zhou X. Effects of orthokeratology on choroidal thickness and axial length. Optom Vis Sci. 2016 Sep;93:1064-1071.
- Li Z, Cui D, Hu Y, Ao S, Zeng J, Yang X. Choroidal thickness and axial length changes in myopic children treated with orthokeratology. Cont Lens Anterior Eye. 2017 Dec;40:417-423.
- Anstice NS, Phillips JR. Effect of dual-focus soft contact lens wear on axial myopia progression in children. Ophthalmology. 2011 Jun;118:1152-1161.
- Walline JJ, Greiner KL, McVey ME, Jones-Jordan LA. Multifocal contact lens myopia control. Optom Vis Sci. 2013 Nov;90:1207-1214.
- Chua WH, Balakrishnan V, Chan YH, et al. Atropine for the treatment of childhood myopia. Ophthalmology. 2006 Dec;113:2285-2291.
- Chia A, Lu QS, Tan D. Five-year clinical trial on atropine for the treatment of myopia 2: Myopia control with atropine 0.01% eyedrops. Ophthalmology. 2016 Feb;123:391-399.
- Polling JR, Kok RG, Tideman JW, Meskat B, Klaver CC. Effectiveness study of atropine for progressive myopia in Europeans. Eye (Lond). 2016 Jul;30:998-1004.
- Sander BP, Collins MJ, Read SA. The interaction between homatropine and optical blur on choroidal thickness. Ophthalmic Physiol Opt. 2018 May;38:257-265.
- Zhang Z, Zhou Y, Xie Z, et al. The effect of topical atropine on the choroidal thickness of healthy children. Sci Rep. 2016 Oct 7;6:34936.
- Chiang ST, Phillips JR. Effect of atropine eye drops on choroidal thinning induced by hyperopic retinal defocus. J Ophthalmol. 2018 Jan 14;2018:8528315.




